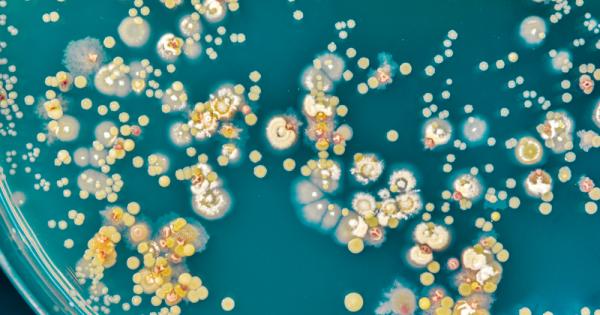
Бактериалните колонии по скоро биха извършили еволюционно самоубийство отколкото да се

... новини по този въпрос, не мога да споделя нищо.“Слот: Когато наш футболист падне в наказателното поле, никога не следва дузпа, с другите отбори е различно
Към Онези - Новини
Чувствах се че тези които загубихме тази година бяха многобройни
...... от „Get Smart“; и Малкълм Джамал Уорнър от "Шоуто на Козби". Трудно е да си помислим някой от тях да остарее. Вземете телевизионния Денис Заплахата:
На Никулден – деня в който България свежда глава пред
...... море, желая да имат у дома една Пенелопа, чиито молитви към свети Николай да ги връщат живи и здрави на брега.Бъдете честити и горди!06.12.2025 г.
ВАШИНГТОН AP — САЩ наложиха санкции в сряда на предполагаеми
...... да отрежем тези терористи от САЩ и световната финансова система и да запазим американските граждани в безопасност.“___Хорхе Руеда в Каракас, Венецуела допринесе за този доклад.
България има достатъчно много бензиностанции складове и възможности логистично да
...... нищо да направят по въпроса, точно както техният ментор на времето нищо не можа да направи и просто продаде компанията на руснаците", допълни Виктор Димчев.
Вижте всички теми Връзка копирана Следвайте Вицепрезидентът Дж Първата поправка
...... подкрепя телевизионното изпитание на Тайлър Робинсън, заподозреният в стрелбата на Кирк, Ванс отговори: „Това ме поразява като добра идея.“ Вижте всички теми Връзка копирана! Следвайте
Вашингтон AP Съобщението на администрацията на Тръмп тази седмица
...... & Block - заведе дело във федералния съд, за да блокира изпълнението на заповедите и във всеки случай надделяваше да ги удари, оставяйки разрешенията непокътнати.
Онези които искат край на войната без победа над Хамас
...... Вие можете да допринесете за нашия стремеж към истината, неприкривана от финансови зависимости. Можете да помогнете единственият поръчител на съдържание да сте вие – читателите.
Олбани Ню Йорк AP Очаква се Ню Йорк да
...... се разбере, че то планира да се насочи и е насочен към хората, с които не е съгласен, и това много включва протестиращи“, каза Бом.
За контрабандния скандал в Пловдив и защо деуптатите не изслушаха
...... че статуквото си остава?Има такива белези. Най-странното е, че това е станало по времето на кабинета "Главчев".Последният служебен кабинет беше назначен от президента, нали така?
Онези които се опитват да си мият ръчичките с Делян
...... е кметът на Симитли Апостол Апостолов. Източник: БНР Още новини четете в: България, Темите на деня За още актуални новини: Последвайте ни в Google News
Директорът на ЦРУ Джон Ратклиф се сблъска с демократичен сенатор
...... Бреан Депиш е репортер на политиката на Fox News Digital, обхващащ администрацията на Тръмп, с акцент върху Министерството на правосъдието, ФБР и други национални новини.
Министерството на родината DHS Секретарят по сигурността Кристи Ноем се
...... писателка за новини за Fox News Digital. Преди да се присъедини към Fox News, Александра обхвана разбиването на новини, престъпността, религията и военните на югоизток.
60 тият рожден ден може да е повод за тъга Старостта
...... Притежава една от най-богатите колекции ръчни часовници в Европа. И, очевидно, Zegna го смятат за много подходящ за рекламно лице.A post shared by ZEGNA (@zegna)
Снимката на Водещия показва Лорънс Фокс чакащ да се качи на
...... отбранителна лига публикува постоянен поток от подстрекателни публикации в социалните медии от задграничния си затвор, докато е на почивка със семейството и приятелите си .
Актьорът Ашли Джъд добавя гласа си към призивите към президента
...... не върна веднага съобщение с искане за коментар на статията на Ашли Джъд.___Kinnard съобщи от Чапин, Южна Каролина и можете да го намерите на http://twitter.com/MegKinnardAP.
Мила Кунис и Аштън Къчър излязоха на вечеря с брата
...... след новите. „Мила няма да позволи на Аштън да има какъвто и да било контакт. Той очаква призовка, тъй като са добри приятели от 20 години.
Бележка на редактора е телевизионен продуцент носител на награда Еми
...... говорят за опасностите от повторно обвързване с Тръмп. И се надяваме, че някои американци - особено в тези критични суинг щати - ще се вслушат.
Полският премиер Доналд Туск се зарече че няма да има снизхождение
...... "Туитър", по повод арестите. "Няма да има снизхождение към сътрудниците на руските служби. Ще пресечем всеки акт на предателство и опит за дестабилизация", добави той.
Комикът Хелън Ледерер откровено разкри че е била пристрастена към
...... на връзката, двойката се сдобри и няколко години по-късно той я избра в Шоуто на Хари Енфийлд, играейки проститутка.Сега тя е омъжена за съпруга Крис Браун.
СподелиОт Козлодуй премиерът в оставка Николай Денков отговори на упреците
...... можем да седнем да преговаряме. Ако не сме готови, отиваме и връщаме мандата“, заяви още Борисов.За още интересни новини, интервюта, анализи и коментари харесайте !
Имаме готовност с основните точки в новия меморандум който предлагаме
...... подготвят седем законопроекта, които са в напреднала фаза, добави Денков. И заяви, че имат подкрепата по недоговорените доставки на слънчоглед от Украйна. Очаквайте още подробности.
Двадесет и шест бейзболни легенди се състезават да бъдат въведени
...... момента той седи на 75% в публичните гласове. Новите участници в Залата на славата ще бъдат въведени в Cooperstown на 21 юли по-късно тази година.
Талибаните призовават частния сектор в Афганистан да помогне на онези
...... се случва в момента, ще има отрицателно въздействие върху отношенията между двете страни“. Водещи историиKaitlin Armstrong бившият приятел на 'с свидетелства за ' бурна връзка
ЧЕСТИТ ПРАЗНИК БЪЛГАРИ 1 ноември Ден на народните ни Будители Ден
...... - духовници, учители, писатели, общественици, културни и читалищни дейци. Всички Вие, които пазите, цените и надграждате културното, просветно и духовно дело на предците ни!Честит празник!
На зърноолигарсите които държат да бъдат наричани зърнопроизводители не из
...... приема ни в ЕС… Украйна не ни е виновна за нищо. Много подло е да бъде нападана с лъжи и манипулации, заради интересите на агресора. Огнян Стефанов
Това написа културологът и университетски преподавател проф Ивайло Дичев Вижте
...... Ами няма да преговарят, защото целта е всичко да си остане постарому. Хайде този път да не е пак така!" *** Автор: проф. Ивайло Дичев, Дойче веле
Но тези които днес отказват да преговарят с правителството са
...... Но нека излязат резултатите, и пак ще си говорим. Политологът проф. д-р Татяна Дронзина, дългогодишен преподавател в катедрата по политология в СУ „Св. Климент Охридски“, Facebook
Колкото представители на различни организации съсловия институции анализаторски центрове и
...... си зърнар, за да разбираш това. Както не е задължително да си зърнар и в проект на президента, за да милееш за страната си. Емил Азар
Това че няма опонент на ГЕРБ за нас не е
...... бюджетът е изключително важен инструмент за управлението на града. Много бързо ние ще подготвим, включително по нов модел, бюджетът за 2024 г., заяви Борис Бонев.
Държавната ТАСС съобщава че Лавров е участвал в кръгла маса
...... на Зеленски „само в онези точки, които му харесват”, което според него е "опит нормалните държави да бъдат въвлечени в абсолютно нереалистично, русофобско, ултимативно начинание".
Георги Лапчев кметът на община Царево в интервю за предаването
...... животът е това да си подаваме ръка в добри и в лоши моменти, защото именно такива тежки ситуации показват на обществото кои са истинските хора.
Те отговориха на 11 септември като офицери, сега се отнасят към онези, които стояха до тях
...... публикуван на 12 септември 2021 г. и е продуциран от Кийт Зуброу. Той беше редактиран от Сара Шафър Предигер. Мейбъл Кабани беше сътрудник по излъчването.
Руските въздушни удари в Украйна показват за пореден път че
...... каза говорителят. Повтарям настоятелния призив на ЕС към Русия да не използва подобни поводи като оправдание за допълнително задълбочаване на войната срещу Украйна, допълни той.
България е разделена това се вижда и на улицата Трябваше
...... отбеляза Кузман Илиев. Според него спешно трябва да се приеме удължаване на бюджета. И изрази надежда в близките няколко месеца да се сформира редовен кабинет.
Ще бъдем безкомпромисни към онези които се възползват от ситуацията
...... вицепремиера и министър на транспорта и съобщенията Христо Алексиев, министъра на земеделието Явор Гечев и министъра на икономиката и индустрията Никола Стоянов може да видите
1 Отговаряйки на въпросите които задават вашите деца не забравяйте
...... една райска ябълка и не умее да отличава доброто от злото. Автор ~ Григорий Остер, Еsquire.ru Снимки ~ Dustin Hoffman and Justin Henry - Kramer vs. Kramer
Във Велики вторник на Страстната седмица в църквата се чете
...... Светител Николай (Велимирович) Сръбски От книгата: "За трите най-важни неща" Изображения: Wikipedia; заглавно - The Parable of the Ten Virgins (section) by Phoebe Traquair, Mansfield Traquair Church, Edinburgh
Бактериалните колонии по скоро биха извършили еволюционно самоубийство отколкото да се
...... ефективно, а това от своя страна да ги насочи към създаването на нов тип лечения, казва Мофет. Изследването е публикувано в PLOS Computational Biology. Източник: Science Alert
Десетки цивилни все още са в неизвестност ден след като
...... бъдат подведени под отговорност за терора: и тези, които убиват, и тези, които помагат да се убива", подчерта украинският президент Володимир Зеленски, цитиран от БНР.
Беларуският президент Александър Лукашенко каза че е настъпило време властите
...... живеят тук при нас, има дълбоко разкаяли се хора, които разбират, че са сбъркали. Те не трябва да бъдат изхвърлени зад борда", каза беларуският президент.
Беларуският президент Александър Лукашенко каза че е настъпило време властите
...... борда", каза беларуският президент.По думите му, в края на краищата много хора са започналида разбират, че те не са нужни никъде, освен на своята земя.
Беларуският президент каза че е настъпило време властите и обществото
...... каза беларуският президент. По думите му, в края на краищата много хора са започнали да разбират, че те не са нужни никъде, освен на своята земя.
Онези които пипат Изборния кодекс очевидно бутат страната към избори
...... ще бъде премахването на смесеното гласуване и пълното връщане на машините, посочи Даниел Лорер.„Има и трети мандат, така че възможностите не са изчерпани“, заяви той.
Онези които бутат Изборния кодекс бутат страната към избори обичайните
...... "Продължаваме промяната", за да започнат отново диалог, е да бъдат изтеглени промените в Изборния кодекс и по-конкретно - смесеното гласуване: с машини и хартиена бюлетина.
Имаме обичайните заподозрени ГЕРБ ДПС и БСП които се занимават
...... въпросите на българските депутати и казаха няколко интересни неща - няма затваряне на централи, има затваряне на емисии. Няма ПВУ без съдебна реформа", каза той.
&17:21:22)









&format=webp)